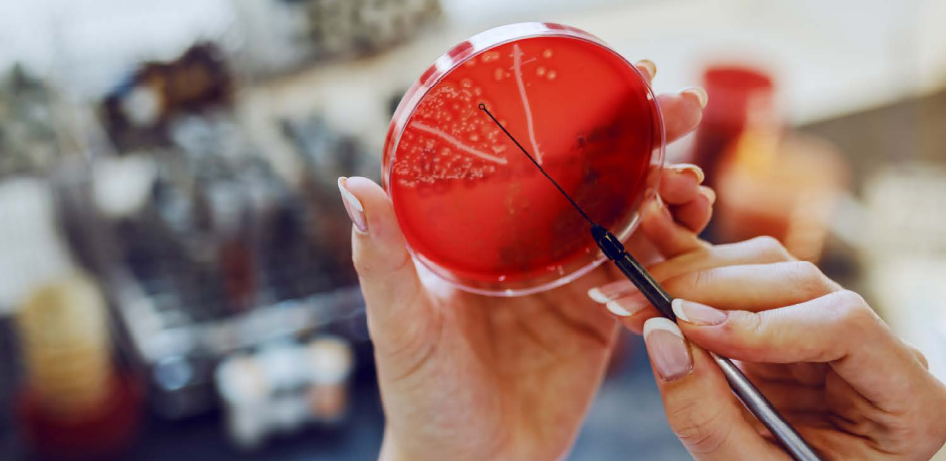

“L’antibiotico resistenza è un problema globale, è una vera e propria pandemia che sta andando avanti da anni e che continuerà ad andare avanti per molti anni. L’Italia è uno dei Paesi che sta pagando lo scotto maggiore. Basti pensare che ogni anno in Italia muoiono quasi 11.000 persone per colpa di infezioni dovute a germi multiresistenti e questo, evidentemente, dà la dimensione del problema e del suo impatto non solo in termine di decessi, ma anche a livello economico e di sanità pubblica” così il Prof. Massimo Andreoni, direttore scientifico della società di malattie infettive SIMIT, definisce il tema della antimicrobial resistance (AMR).
“La letteratura evidenzia come l’approccio corretto all’antibiotico-resistenza sia un approccio che affronta il problema sotto tutti gli ambiti; quindi dalla sanificazione ambientale, al comportamento delle persone, a quello che è il controllo dell’antibiotico terapia, senza fare a meno di un adeguato controllo del rischio” continua Andreoni a margine del Congresso SIMIT 2021.
Negli ultimi anni è stata più volte segnalata la difficoltà, causata dalla mancanza di nuovi antibiotici, nel trattare le infezioni da germi multiresistenti.
Poiché l’AMR è una minaccia globale, le autorità di regolamentazione nell’Ue, negli Stati Uniti e in Giappone hanno concordato – fa sapere l’Agenzia europea – di allineare il più possibile i rispettivi requisiti in materia di dati in modo che gli sviluppatori di medicinali possano progettare studi clinici che soddisfino le esigenze di prove di più agenzie di regolamentazione. Il documento rivisto (rispetto alla edizione precedente – ndr) riflette l’esito di queste discussioni e include anche:
- chiarimenti sui programmi di sviluppo clinico raccomandati per gli antimicrobici destinati a far fronte a un’esigenza insoddisfatta;
- linee guida sugli studi clinici per supportare il trattamento delle infezioni del tratto urinario non complicate e della gonorrea non complicata;
- guida aggiornata sulla visualizzazione dei dati di efficacia microbiologica e clinica nel riassunto delle caratteristiche del prodotto”.
Le linee guida riviste sono pubblicate insieme a un “addendum” volto a guidare i programmi di sviluppo clinico necessari per supportare l’autorizzazione dei medicinali per il trattamento delle infezioni batteriche nei bambini.
Fonte:
SIMIT -XX Congresso SIMIT – Infezioni batteriche
Panorama della Sanità – 26 maggio 2022
EMA – Guideline on the evaluation of medicinal products
indicated for treatment of bacterial infections -19 maggio 2022
EMA – Addendum to the guideline on the evaluation of medicinal
products indicated for treatment of bacterial infections to
address paediatric-specific clinical data requirements – 19 maggio 2022
Articoli correlati:
Fedaiisf – 18 nov 2021 – Giornata europea sull’uso consapevole degli antibiotici